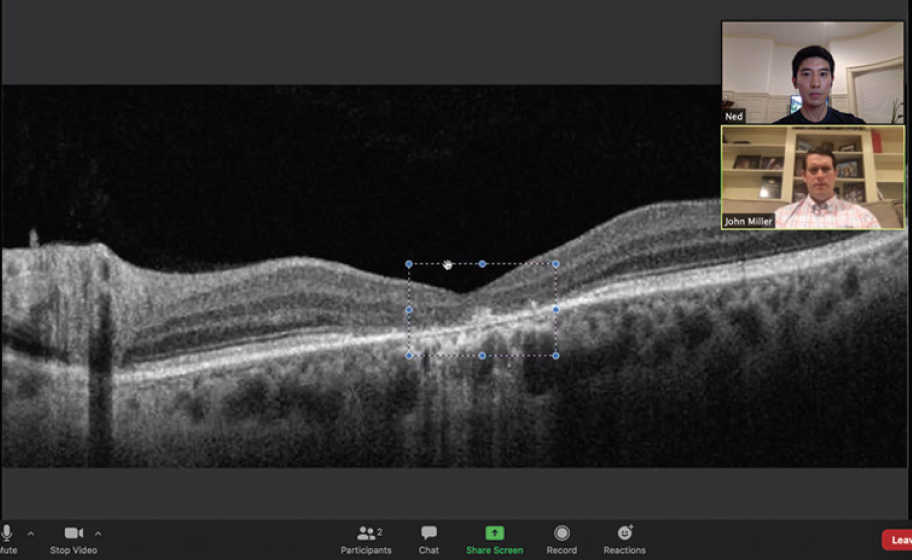
<p>Figure. In a Zoom for Healthcare video call with a retina patient (in this example, the author Edward S. Lu, BA), the screen sharing feature allows display of an OCT image.</p>

The COVID-19 pandemic has magnified the issues facing access to specialty care in retina and ophthalmology. With social distancing measures in place, retina specialists must remotely meet the needs of complex patients while accurately diagnosing them and treating their diseases. Although it has not yet been widely adopted in routine practice, teleophthalmology has the potential to increase access to care, decrease costs, and improve outcomes for patients when in-person visits are not feasible.1
AT A GLANCE
- Changes to CMS regulations and improved telehealth conferencing platforms have arrived to meet the COVID-19 pandemic.
- Hybrid Tele-EyeCare (HyTEC), model for teleophthalmology, combines in-office advanced imaging with virtual patient-physician consultation.
- Barriers to implementation include assurances that reimbursements will continue into the future as well as patient comfort with this new medium and new technologies.
NASA demonstrated one of the first applications of teleophthalmology in 1987, when astronauts’ retinal vessels were monitored in real time during space flights with the use of a portable video fundoscope.2 Telemedicine has been applied at the domestic and global levels to detect retinopathy of prematurity and diabetic retinopathy, with a focus on rural and underserved urban areas as well as developing nations with limited resources for systematic screening and monitoring.3,4 It has also been used in monitoring glaucoma.5
Given the aging population in the United States, an expansion of telemedicine applications for monitoring and treating eye disease may help to improve compliance and reduce the burden of vision loss on the country’s health care system. The COVID-19 crisis, because it demands innovative solutions for clinical care delivery, has accelerated the need for and implementation of long-standing principles of teleophthalmology.
A hybrid telemedicine/in-person approach may have the greatest impact during the COVID-19 crisis and after it subsides. In order to have a robust conversation about the potential of teleophthalmology, clinicians and leaders must first understand the potential telemedicine platforms, the related billing and reimbursement concerns, and the ways telemedicine may continue to prove fruitful to patients and providers in the future.
TELEMEDICINE PLATFORMS
During the COVID-19 crisis, telemedicine has allowed retina specialists in various practice environments to remotely perform follow-up visits and consultations, allowing patients to avoid busy offices and exposure to the coronavirus.
Figure. In a Zoom for Healthcare video call with a retina patient (in this example, the author Edward S. Lu, BA), the screen sharing feature allows display of an OCT image.
Improvements in videoconferencing platforms allow them to be used for high-quality virtual interactions between patients and providers. The general population’s increased exposure during the past decade to video-based communication with friends and family via platforms such as Facetime and Google Duo has made patients more accepting of video consultations. Zoom for Healthcare offers improved privacy (ie, multilayer security with AES-256 encryption), integration with Epic electronic health record (EHR) applications, and the ability to use enhanced collaboration features such as screen-sharing and annotations (Figure).6 Privacy in a health care setting remains paramount. One should note that Zoombombing, wherein unwanted third parties gain access to Zoom meetings, has occurred on the free version of Zoom.
Application- and browser-based telehealth platforms each have advantages and drawbacks. Application-based platforms such as EyecareLive are easy to use and allow patients to check in ahead of time. However, patients need to download and install the application, which may be challenging for some. With browser-based platforms such as doxy.me, patients are provided with a URL for connection, which may be easier.
A HYBRID APPROACH
COVID-19 has changed all of our lives since mid-March, but some of the most important changes to health care occurred in early March.
On March 6, CMS announced an expansion of telemedicine coverage and reimbursement, along with several key regulatory changes. These changes extended telemedicine coverage to all Medicare beneficiaries. Previously, the use of telemedicine was restricted to rural and underserved populations. CMS now considers telehealth visits the same as in-person visits, and reimbursements for telehealth video visits are the same as for in-office visits. This change has allowed our field to leverage improved video technology against expanded coverage options to minimize exposure to office-based settings.
Traditional clinical workflows included overbooked schedules, long wait times, packed waiting rooms, and patient interaction with multiple staff members. COVID-19 requirements have allowed us to reassess retina clinics. This new reality emphasizes precautions for patients, staff, and physicians that include symptom screening, temperature checking at the door, “virtual waiting rooms” in patients’ vehicles or outside, lighter schedules (to accommodate social distancing), and increased sanitizing measures (ie, performing hand hygiene, wearing masks, etc.).
As patients start seeking medical care, after weeks of stay-at-home orders and mandatory rescheduling of nonemergent patients are lifted, we anticipate a surge in patient volume during the next few months. We need not only to make patients safe, but also to make them feel safe. As precautionary measures and social distancing become a way of life, we must think about new paradigms and protocols that allow us to deliver care while enhancing safety and efficiency.
To accommodate patients in our practice, we have developed a novel hybrid telemedicine approach we call Hybrid Tele-EyeCare (HyTEC). HyTEC combines efficient, in-office advanced imaging with virtual consultation to facilitate diagnosis and decision-making for complex retinal diseases. Within a week of the CMS announcement regarding the changes in telehealth requirements, we piloted this hybrid approach at the Florida Retina Institute, a large retina-only private practice, under the leadership of S.K. Steven Houston III, MD (CEO and co-founder of HealTheia), with his partners Matt Cunningham, MD: Benjamin Thomas, MD; Elias Mavrofrides, MD; Jaya Kumar, MD; and Abdallah Jeroudi, MD, all implementing these visits into their clinics.
In this practice model, Dr. Houston runs two parallel clinics. One is an in-office clinic, for patients who need injections or other routine procedures and for new patients or returning patients with new symptoms.
The approximately 20% to 30% of patients who require chronic disease monitoring (ie, patients with diabetic retinopathy, dry age-related macular degeneration, etc.), are seen via the HyTEC model. While Dr. Houston sees patients at the in-office clinic, one or two technicians are imaging patients at a separate office. Between in-office patients or on a separate day, Dr. Houston connects virtually with the patients who underwent imaging at the remote office.
This hybrid approach makes his in-office clinic lighter and more efficient—patient time spent in the clinic is down to 30 minutes, for example—while still allowing him to consult with the same number of patients, generating revenues similar to an all-in-office consultation model.
The HyTEC approach to telemedicine has been successfully deployed in a multispecialty hospital-affiliated private practice (Palo Alto Medical Foundation) with Dr. Ehsan Rahimy and a large academic center with Dr. John Miller (Mass Eye and Ear). At these multispecialty group practices, the hybrid approach has also worked for ophthalmologists outside of retina. Each site has offered different advantages and obstacles to implementation. Regardless of the practice setting, key steps include:
- a reliable and secure video communication platform
- remote access to retinal imaging, ideally with merged or at least simultaneously accessible databases
- pre-visit education of administrative and clinic staff, physicians, and patients about the new virtual visit workflows
- flexibility to meet patient needs and adequately deliver care in a safe manner
- appropriate patient selection
Hybrid telemedicine platforms such as HyTEC may be viable options for retina practices, given the test-heavy nature of our clinical evaluations. We expect that the hybrid approach will extend further into ophthalmology (eg, comprehensive, cornea, glaucoma) and optometry with time.
BILLING AND REIMBURSEMENT
With the cancellation of elective procedures, retina practices must adapt to patient needs while remaining financially solvent. The loosening of CMS billing restrictions on telehealth services provided an opportunity for retina providers to remotely deliver individualized care.
Under the emergency waiver, CMS temporarily expanded Medicare telehealth coverage to allow patients across the country to receive telehealth services in their homes. Previously, Medicare covered only patients in designated rural areas who left their homes to receive telehealth care at medical facilities. The loosening of billing restrictions encourages providers to explore the use of allowed Medicare telemedicine services, which include outpatient visits for new or established patients (codes 99201-99215), brief (5-10 minutes) virtual check-ins for established patients (G2012, G2010), and e-visits for established patients through an online patient portal (99421, 99422, 99423, G2061, G2062, G2063).7
HyTEC visits allow the physician to bill for E/M or eye code visits based on medical decision-making while also billing imaging (OCT, 92134; and fundus photography, 92250) based on local coverage determinations and Medicare administrative contractor regulations.
Although CMS’s expansion of telehealth coverage is encouraging, maintained reimbursement for virtual visits is necessary, at least in the short to medium term, so that practitioners can continue investing resources into building their telemedicine capacity. Continuing to reimburse virtual visits at parity with office visits will promote telehealth innovation and buy-in.
THE FUTURE OF TELEMEDICINE
When practices again begin to operate at full capacity, telemedicine may help to alleviate a post-outbreak surge in clinic visits. Off-hour and weekend virtual visits can accommodate patients who are concerned about coming into the office with relaxed social distancing measures.
Paradoxically, virtual encounters may force more face-to-face interaction and small talk compared with in-person visits in a busy clinic. Typing into EHR software, dictating to scribes, and interacting in a dark room will not be present during telemedicine consults.
The long-term buy-in to teleophthalmology by patients and providers in the aftermath of COVID-19 remains to be seen. Changing patient management processes, reimbursement concerns, and disruption of traditional practice structures will present barriers to telemedicine implementation. However, among the early adopters coauthoring this article, our experience shows that many patients embrace this change and value its enhanced safety and efficiency.
This quote from one of our patients captures this sentiment: “I’ve been following up with a retina specialist for years. This was the best and most efficient visit I have ever had. Why have you not been doing this before? Can I continue to have all my visits with HyTEC?”
1. Sreelatha OK, Ramesh SV. Teleophthalmology: improving patient outcomes? Clin Ophthalmol. 2016;10:285-295.
2. Li HK. Telemedicine and ophthalmology. Surv Ophthalmol. 1999;44(1):61-72.
3. Friedman DS, Ali F, Kourgialis N. Diabetic retinopathy in the developing world: how to approach identifying and treating underserved populations. Am J Ophthalmol. 2011;151(2):192-194.e1.
4. Mansberger SL, Sheppler C, Barker G, et al. Long-term comparative effectiveness of telemedicine in providing diabetic retinopathy screening examinations: a randomized controlled trial. JAMA Ophthalmol. 2015;133(5):518-525.
5. Rathi S, Tsui E, Mehta N, Zahid S, Schuman JS. The current state of teleophthalmology in the United States. Ophthalmology. 2017;124(12):1729-1734.
6. Video Conferencing, Web Conferencing, Webinars, Screen Sharing. Zoom Video. www.zoom.us. Accessed May 15, 2020.
7. Medicare Telemedicine Health Care Provider Fact Sheet. Centers for Medical and Medicaid Services. March 17, 2020. www.cms.gov/newsroom/fact-sheets/medicare-telemedicine-health-care-provider-fact-sheet. Accessed May 15, 2020.

























